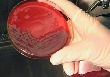
Споры сибирской язвы обнаружены в Курской области

Новости отрасли

|
Споры сибирской язвы обнаружены в Курской области
В Курском районе Курской области выявлены споры сибирской язвы в одном из частных подворий, сообщает ГУ МЧС по региону.
Сообщение в службу спасения об обнаружении опасного заболевания в деревне Первое Цветово поступили в "Службу спасения 112" в минувший вторник от ветеринарной службы, сотрудники которой при обследовании павшей коровы обнаружили споры сибирской язвы.
К месту происшествия были направлены оперативная группа регионального ГУ МЧС, расчет пожарной части, аварийно-спасательная служба, сотрудники полиции, работники Управления Ветеринарии и Роспотребнадзора, бригада медиков.
Специалисты провели дезинфекционные работы в данном подворье, а также вакцинацию крупного рогатого скота в соседних домовладениях.
Угрозы для населения нет, ситуация находится под контролем, отмечается в сообщении.
Сибирская язва - острое инфекционное заболевание животных и человека, вызываемое бациллой сибирской язвы. Возбудитель болезни образует споры, которые способны годами сохраняться в почве и выдерживать кипячение до 1 часа. Для человека основной источник инфекции - больные животные. Заражение может наступить при уходе за ними, вынужденном убое и разделке туши, при употреблении в пищу инфицированных продуктов животноводства (мясо, молоко) и контакте с ними (шерсть, кожа, щетина и т. д.), а также через инфицированные почву и воду.
Фото с сайта news2000.com.ua
Сообщение в службу спасения об обнаружении опасного заболевания в деревне Первое Цветово поступили в "Службу спасения 112" в минувший вторник от ветеринарной службы, сотрудники которой при обследовании павшей коровы обнаружили споры сибирской язвы.
К месту происшествия были направлены оперативная группа регионального ГУ МЧС, расчет пожарной части, аварийно-спасательная служба, сотрудники полиции, работники Управления Ветеринарии и Роспотребнадзора, бригада медиков.
Специалисты провели дезинфекционные работы в данном подворье, а также вакцинацию крупного рогатого скота в соседних домовладениях.
Угрозы для населения нет, ситуация находится под контролем, отмечается в сообщении.
Сибирская язва - острое инфекционное заболевание животных и человека, вызываемое бациллой сибирской язвы. Возбудитель болезни образует споры, которые способны годами сохраняться в почве и выдерживать кипячение до 1 часа. Для человека основной источник инфекции - больные животные. Заражение может наступить при уходе за ними, вынужденном убое и разделке туши, при употреблении в пищу инфицированных продуктов животноводства (мясо, молоко) и контакте с ними (шерсть, кожа, щетина и т. д.), а также через инфицированные почву и воду.
Фото с сайта news2000.com.ua
Теги:
КРС / скотоводство


